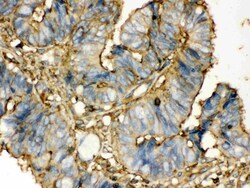
Invitrogen TGM2 Polyclonal Antibody 100 &mu;g; Unconjugated:Antibodies,

Learn More
Invitrogen™ TGM2 Polyclonal Antibody


Rabbit Polyclonal Antibody
Brand: Invitrogen™ PA595256
Description
Reconstitute with 0.2 mL of distilled water to yield a concentration of 500 μg/mL. Positive Control - WB: Rat Liver Tissue, Rat Ovary Tissue, HELA whole cell. IHC: mouse spleen tissue, rat spleen tissue, human intestinal cancer tissue, human mammary cancer tissue IHC-F: mouse spleen tissue, rat spleen tissue, human placenta tissue. Store at -20°C for one year from date of receipt. After reconstitution, at 4°C for one month. It can also be aliquotted and stored frozen at -20°C for six months. Avoid repeated freeze-thaw cycles.
Transglutaminase (TGase) catalyses the crosslink of proteins by forming e-(g-glutamyl) lysine isopeptide bonds and requires the binding of Ca2+ for its activity. In mammals, eight distinct TGase isoenzymes have been identified. Tissue transglutaminase (tTGase), also known as TGase 2, has four distinct domains: N-terminal b-sandwich, catalytic core and two C-terminal b-barrel domains. tTGase may have a role in cell death, cell proliferation, cell differentiation, and receptor-mediated endocytosis. In the Alzheimer's disease brain, the elevated tTGase activity is manifested by polymerization of a number of proteins, including Ab peptide, b-amyloid precursor protein and the tau protein, with formation of neurofibrillary tangles.
Specifications
| TGM2 | |
| Polyclonal | |
| Unconjugated | |
| TGM2 | |
| C polypeptide; C polypeptide, protein-glutamine-gamma-glutamyltransferase; G alpha h; G[a]h; G-ALPHA-h; GNAH; Protein-glutamine gamma-glutamyltransferase 2; protein-glutamine-gamma-glutamyltransferase; RP5-1054A22.2; TG C; TG(C); TG2; TGase C; TGase H; TGase2; TGase-2; TGase-H; TgaseII; TGC; TGM2; Tissue transglutaminase; Tissue type transglutaminase; tissue-type transglutaminase; transglutaminase; transglutaminase 2; transglutaminase 2 (C polypeptide, protein-glutamine-gamma-glutamyltransferase); Transglutaminase 2 C polypeptide; transglutaminase 2, C polypeptide; transglutaminase C; Transglutaminase H; transglutaminase-2; tTG; tTGas | |
| Rabbit | |
| Affinity chromatography | |
| RUO | |
| 21817, 56083, 7052 | |
| -20°C | |
| Lyophilized |
| Immunohistochemistry (Frozen), Immunohistochemistry (Paraffin), Western Blot | |
| 500 μg/mL | |
| PBS with 5mg BSA and 0.05mg sodium azide | |
| P21980, P21981 | |
| TGM2 | |
| A synthetic peptide corresponding to a sequence at the N-terminus of human TGM2 (7-34aa LERCDLELETNGRDHHTADLCREKLVVR). | |
| 100 μg | |
| Primary | |
| Human, Mouse, Rat | |
| Antibody | |
| IgG |
Your input is important to us. Please complete this form to provide feedback related to the content on this product.